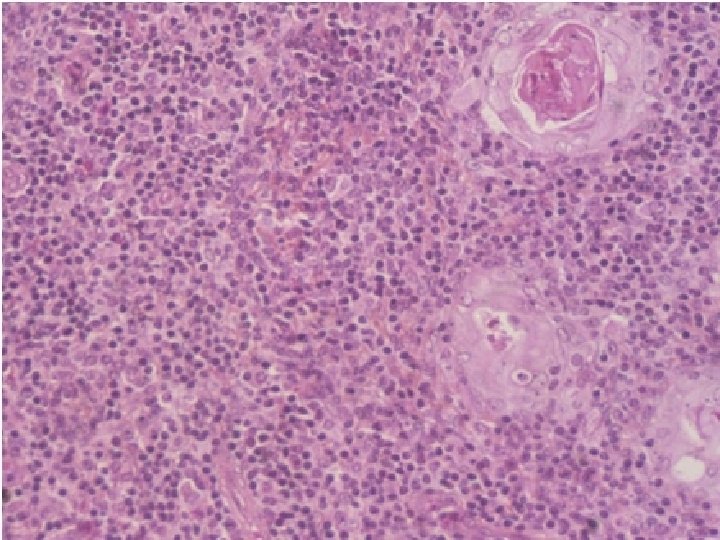

IMMUNE SYSTEM LECTURE FOR MEDICAL STUDENTS DEPARTMENT OF

- Slides: 53
IMMUNE SYSTEM LECTURE FOR MEDICAL STUDENTS DEPARTMENT OF HISTOLOGY, CYTOLOGY AND EMBRYOLOGY Kh. NMU 2012
An Immune system is a collection of biological processes within an organism that protects against disease by identifying and killing pathogens and tumour cells. It detects a wide variety of agents, from viruses to parasitic worms, and needs to distinguish them from the organism's own healthy cells and tissues in order to function properly. Antigen is substance that stimulates the production of an antibody when introduced into the organism. Antigens include toxins, bacteria, viruses, and other foreign substances. Antibodies (also known as immunoglobulins, abbreviated Ig) are gamma globulin proteins that are found in blood or other bodily fluids and are used by the immune system to identify and neutralize foreign objects, such as bacteria and viruses.
The major components of the immune system are: • Immunocompetent cells • Antibodies • Complement system • Bone marrow • Thymus • Spleen • Lymph nodes • Tonsils
Immunocompetent cells: 1. T-lymphocytes {T-helper, T-suppressor, T-cytotoxic (killer cells), T-memory cells} 2. Natural killer cells(NK-cells) 3. B-lymphocytes 4. Plasma cells 5. Macrophages 6. Granulocytes of the blood(Neutrophilic, Eosinophilic, Basophilic Leucocytes) 7. Monocytes 8. Mesenhymal reticular cells 9. Epithelial reticular cells 10. Antigen Presenting Cells (APC) {Dendritic cells, Langerhans’ cells of the skin, Kupffer’s cells of the Liver, Dust cells of the Lung etc. )
BONE MARROW The marrow of all bones begins as active hematopoietic tissue or red marrow(RBM). During growth, development, and aging, portions of the active red marrow are replaced by adipocytes to form yellow marrow(YBM). 1. Stroma consists of adipocytes (up to 75% of red marrow), macrophages, and reticular connective tissue composed of reticular cells, adventitial cells and the reticular fibers (type III collagen). Adventitial cells are highly branched, poorly differentiated mesenchymal derivatives resembling fibroblasts. Their processes separate the developing blood cells from the endothelium of the bone marrow sinusoids.
2. Hematopoietic cords fill the interstices of the stroma and are crowded with overlapping blood cells of all types and at all stages of differentiation. RBM is composed of interdigitating masses of stroma and hematopoietic cords. 3. Abundant sinusoids lie between the cords and have openings in their walls through which maturing blood cells and platelets enter the circulation. In histologic section, the dense packing of the cells makes identification of individual cell types difficult. Thus, differentiating blood cells are commonly studied in smears. 4. Erythroblastic islands are clusters of developing erythrocytes surrounding macrophages and receiving iron from them.
Bone marrow functions 1. Hematopoiesis. 2. Bone marrow helps destroy old red blood cells. Macrophages in the bone marrow, spleen, and liver break down hemoglobin to form (1) globin, which is quickly hydrolyzed; (2) porphyrin rings, which are coverted to bilirubin; and (3) iron, which is complexed with and transported by the plasma protein transferrin to the bone marrow for reuse by developing erythrocytes. It is located in cytoplasmic vacuoles termed siderosomes. 3. Recirculation of the blood and immunocompetent cells. 4. Depot of the blood 5. Immune protection(defence)
Hematopoietic Bone Marrow Stem Cells Stem cells can differentiate into many different cell types How does it decide what to become?
Bone Marrow • Bone marrow is a general term for the soft tissue occupying the medullary cavity of a long bone, the spaces amid the trabeculae of spongy bone, and the larger haversian canals. • There are 2 main types: red & yellow. • Red bone marrow = blood cell forming tissue = hematopoietic tissue • Red bone marrow looks like blood but with a thicker consistency. • It consists of a delicate mesh of reticular tissue saturated with immature red blood cells and scattered adipocytes. Notice the red marrow and the compact bone
Distribution of Marrow • In a child, the medullary cavity of nearly every bone is filled with red bone marrow. • In young to middle-aged adults, the shafts of the long bones are filled with fatty yellow bone marrow. – Yellow marrow no longer produces blood, although in the event of severe or chronic anemia, it can transform back into red marrow • In adults, red marrow is limited to the axial skeleton, pectoral girdle, pelvic girdle, and proximal heads of the humerus and the femur.
Classification of Lymphoid Tissues and Organs: In peripheral lymphoid organs (lymph nodes, spleen, tonsils) and unencapsulated lymphatic aggregates, lymphocyte production is antigen-dependent and provides committed immunocompetent cells that respond to specific antigens. In central lymphoid organs (thymus, bone marrow, bursa of Fabricius [in birds]), lymphocyte production is antigenindependent and supplies uncommitted T lymphocyte (thymus) or B lymphocyte (bone marrow, bursa) precursors that later move to peripheral organs and tissues. Mounting effective immune responses to new antigens requires ongoing production of uncommitted lymphocytes by the central lymphoid organs.
Lymphoid Nodules (Follicles): These occur in all lymphatic aggregates except the thymus. Active (lymphocyte-producing) nodules each have a darkstaining periphery, or mantle zone, that contains tightly packed small lymphocytes, and a light-staining core, or germinal center, that contains numerous immunoblasts (lymphoblasts), ie, lymphocytes stimulated by antigens to enlarge and proliferate. The lighter staining reflects the increased cytoplasmic volume and decreased nuclear heterochromatin that accompany lymphocyte activation.
Lymph Nodules
Ileum, Nodule
Lymphatic Nodule n n “Non-capsulated” Single or aggregated Independent OR parts of lymphoid organs Outer dark zone n n (Corona or cap) Germinal centre
Peyer’s Patches Smaller aggregates present under many mucous membranes : “Mucosa Associated Lymphoid Tissue” or MALT
Lymph node Lymphatic nodule Fig. 22. 12 a(TECapsule Art) Afferent lymphatic vessel Trabecula Efferent lymphatic vessel
Lymph Node Fig. 21. 12 a and b 23
Lymph Node • • • Capsulated Afferent lymphatics “subcapsular sinus” Hilum – blood vessels, efferent lymphatic Cortex and medulla Cortex – Lymphatic nodules, germinal centres – “Paracortex” T-dependent zone • Medulla – Medullary cords and sinusoids M C
C M
LYMPH NODES These are the smallest but most numerous encapsulated lymphoid organs. Scattered in groups along lymphatic vessels , they act as in-line filters of the lymph, removing antigens and cellular debris and adding Igs. Lymph nodes are bean-shaped structures with convex and concave surfaces. The parenchyma consists of a peripheral cortex, adjacent to the convex surface, and a central medulla lying near the depression (hilum) in the concave surface. The connective tissue capsule gives off trabeculae that penetrate between the cortical nodules and subdivide the cortex. Cortex. The cortex is dark-staining owing to the presence of tightly packed lymphocytes. These are suspended in a reticular connective tissue network and arranged as a layer of typical secondary lymphoid nodules (containing primarily B lymphocytes) with germinal centers. The cortex also contains reticular cells, antigen-presenting follicular dendritic cells, macrophages, a few plasma cells, and some helper T cells.
Medulla. Lighter staining than the cortex, the medulla is composed of cords of lymphoid tissue (medullary cords) separated by medullary sinuses. The lymphocytes are mainly small, less numerous than in the cortex. The cords are also rich in reticular cells and fibers and contain many plasma cells that have migrated from the cortex. Paracortical zone. This is the T-dependent region, lying between the cortical lymphoid nodules and the medulla. It contains mainly T lymphocytes suspended in a reticular connective tissue. B lymphocytes, plasma cells, macrophages, and antigen-presenting interdigitating dendritic cells may also be present. Lymphatic vessels. Sinuses (subcapsular, peritrabecular, medullary). Functions: 1. Filtration of lymph 2. Lymphocyte production (lymphopoiesis). 3. Immunoglobulin production.
Lymph Node
Lymph Node
SPLEEN The largest of the lymphoid organs. Splenic pulp is composed of many erythrocytes, leukocytes, and macrophages, as well as a variety of blood vessels, all suspended within a meshwork of mesenchymal reticular cells and fibers. White pulp consists of the lymphoid tissue surrounding each of the many central arteries; it has 2 major components. The sleeves of lymphoid tissue immediately surrounding each central artery are called periarterial lymphatic sheaths (PALS). These contain mainly T lymphocytes and constitute the T-dependent regions of the spleen. Surrounding each PALS, or appended to one side, is the second component, the peripheral white pulp (PWP). PWP contains mainly B lymphocytes and usually includes a typical secondary lymphoid nodule with a germinal center.
Red pulp makes up most of the spleen and also has 2 major components: the red pulp cords and the splenic sinusoids that lie between them. The red pulp (Billroth’s) cords are irregular sheets of reticular connective tissue that branch and anastomose to surround the sinuses. In addition to reticular cells and fibers, the cords contain many cell types, including all the formed elements of blood, dendritic cells, macrophages, plasma cells, and lymphocytes. Splenic sinusoids differ from common capillaries: the lumen is wider and more irregular; there are 2 -3 - m spaces between the lining endothelial cells; and there is a sparse, discontinuous basal lamina that is composed largely of reticular fibers arranged in bands that run roughly perpendicular to the length of the vessel. The marginal zone forms a border between the white and red pulp; it consists of a moatlike arrangement of blood sinuses and loose lymphoid tissue containing few lymphocytes.
Spleen 35
Open and closed theories of splenic circulation. Blood in the capillaries reaches the sinusoid lumens by two ways. The closed theory holds that the capillary walls are continuous with the walls of the sinusoids and that the capillaries empty directly into the sinusoid lumens. The open theory holds that the capillaries end abruptly in the red pulp cords and that blood reaches the sinusoid lumens by percolating through the cords and passing through openings in the sinusoid walls. For humans, current evidence favors the open theory. Central arteries and open blood circulation are unique feature for the spleen. Functions: 1. Filtration of blood. 2. Lymphocyte production (lymphopoiesis). 3. Destruction of worn red blood cells 4. Extramedullary hematopoiesis.
Thymus is the only discrete central lymphoid organ in humans. It produces only T lymphocyte precursors and has no lymphoid nodules. Its reticular cells derive from endoderm and produce no reticular fibers. It is the only organ containing Hassall’s corpuscles. Its age-dependent structural atrophy or involution is also unique among lymphoid organs. 2 lobes are joined and covered by a thin loose connective tissue capsule that penetrates the lobes as septa, dividing each lobe into incomplete lobules. Cortex. This is the dark-staining periphery of each lobule. Small lymphocytes predominate
Medulla. In effect, each thymic lobe has a single medulla that extends into the core of each of the lobules. The light staining of the medulla reflects the presence of more epithelial reticular cells and fewer lymphocytes than in the cortex. The spheric Hassall’s corpuscles (30 -150 m in diameter) are composed of concentric layers of flattened epithelial reticular cells. With age, cells in the core of the corpuscles may die and calcify. Functions: 1. T lymphocyte production. 2. Blood -thymus barrier. 3. Production hormone - thymosin
Histology of Thymus 40
Thymus • • n Hassal’s Corpuscles Capsule Lobules Cortex Medulla
Differentiation Figure 5 -3 part 1 of 2 Immature thymocytes are here More mature thymocytes are here
Figure 5 -3 part 2 of 2
The Human Thymus Involutes With Age Fetal Thymus Adult Thymus
INVOLUTION OF THE THYMUS Two types: 1. Age dependent 2. Accidental involution due to some exogenous agent, such as chemical or radiation insult or severe chronic infections
TONSILS These incompletely encapsulated lymphoid aggregates contain many lymphoid nodules; they underlie the mucous membranes (epithelial lining) of the mouth and pharynx. Together with the diffuse subepithelial lymphoid tissue that connects them to form a ring, they guard the common entrance to the digestive and respiratory tracts. The 3 types, palatine tonsils, the pharyngeal tonsil, and lingual tonsils, differ in number, epithelial covering, presence (or absence) and number of epithelial invaginations or crypts, and presence (or absence) of a definitive partial capsule. Most specific structures: epithelial linings, lymphatic nodules under the epithelium with lymphatic infiltration and crypts.
Tonsils
Tonsil
Palatine Tonsil